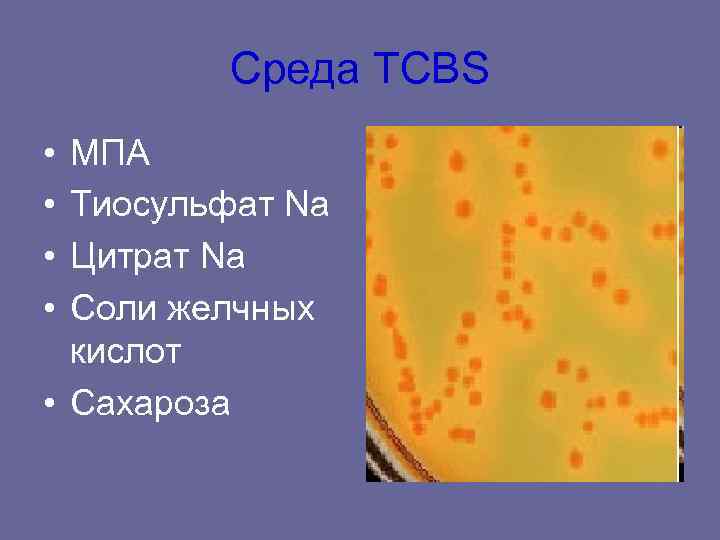
Среда TCBS • МПА • Тиосульфат Na • Цитрат Na • Среда TCBS • МПА • Тиосульфат Na • Цитрат Na •

Холера (от латинского cholera) — острая кишечная антропонозная

Kholera.ppt
- Количество слайдов: 14
Холера (от латинского cholera) — острая кишечная антропонозная инфекция, вызываемая бактериями вида Vibrio cholerae. Характеризуется фекально-оральным механизмом заражения, водянистой диареей, рвотой, быстрейшей потерей организмом жидкости и электролитов с развитием гиповолемического шока.
Классификация • Семейство Vibrionaceae • Род Vibrio • Вид Vibrio cholerae • Серовары: • Vibrio choleraе cholerae • Vibrio cholerae eltor • O 139 «Бенгал»
Характеристика возбудителя • Слегка изогнутая палочка, имеет один полярно расположенный жгутик. Подвижен. • Грамотрицателен, спор не образует. • Не требователен к питательным средам. Температурный оптимум 37 о, оптимум РН – 7, 6 – 8, 0. • Истинные вибрионы разлагают маннозу и сахарозу и не разлагают арабинозу (триада Гейберга), разжижают желатин, расщепляют белки до аммиака и индола. Н 2 S не образуют. • Серовары: Возбудители классической холеры и холеры Эль-тор объединяются в серогруппу О 1 (различные сочетания А, В и С-субъединиц О 1 - антигена) – АВ – серовар Огава, АС – Инаба, АВС – Гикошима.
Культуральные свойства • На 1% щелочной пептонной воде (РН=9, 0) опережают рост энтеробактерий и через 6 часов образуют голубоватую поверхностную пленку, которая разрушается при встряхивании. • На щелочном агаре образуют мелкие круглые прозрачные S-колонии с ровными краями, маслянистые, голубоватые в проходящем свете. • Среда Мансура - гидролизат казеина обеспечивает присутствие важнейших нутриентов для бактерий. Таурохолат натрия подавляет рост сопутствующих грамположительных бактерий. Теллурит калия – селективный и дифференцирующий компонент. Он подавляет рост многих грамположительных бактерий и придает (за счет восстановления теллурита) черный или серый цвет выросшим колониям. Карбонат натрия обеспечивают буферные свойства среды, а хлорид натрия – оптимальное осмотическое давление. Желатин является дополнительным источником углерода и энергии. • На агаре с тиосульфатом, цитратом, солями жёлчных кислот и сахарозой (TCBS-arap) V. cholerae ферментирует последнюю и образует жёлтые колонии.
Среда TCBS • МПА • Тиосульфат Na • Цитрат Na • Соли желчных кислот • Сахароза
Факторы патогенности V. Cholerae • Адгезины: жгутик, ЛПС • Ферменты патогенности: муциназа (разжижает слизь и обеспечивает доступ к энтероцитам); нейроминидаза (усиливает связывание холерного экзотоксина с эпителием слизистой кишечника) • Эндотоксин: через запуск каскада арахидоновой кислоты стимулирует синтез простагландинов (Е, F), вызывающих сокращение гладкой мускулатуры ТК и подавляющих иммунный ответ • Экзотоксин (энтеротоксин) холероген: Клетки-мишени – энтероциты. Компонент А активизирует внутриклеточную аденилатциклазу, что приводит к повышению содержания ц. АМФ и к выходу экстрацеллюлярно электролитов и жидкости в просвет кишечника.
Эпидемиология холеры • Источником инфекции является больной с манифестным или бессимптомным течением заболевания. Наиболее активными вибрионовыделителями являются больные с тяжелым течением заболевания, выделяющие до 10 л испражнений в сутки, в каждом миллилитре которых содержится до 109 вибрионов. В то же время больные с бессимптомным и стертым течением холеры, при отсутствии своевременной диагностики, выделяют возбудитель во внешнюю среду длительное время. Предполагается существование хронических, иногда пожизненных, вибриононосителей. • Механизм заражения холерой - фекально-оральный. Пути передачи - водный, алиментарный, контактно-бытовой. Водный путь имеет решающее значение для быстрого эпидемического и пандемического распространения холеры. При этом не только питье воды, но использование ее для хозяйственных нужд (мытье овощей, фруктов и т. п. ) может приводить к заражению холерой. • Фактором временного резервирования возбудителя могут являться рыбы, креветки, моллюски, которые способны накапливать и сохранять холерные вибрионы. • Наиболее восприимчивы к холере иммунокомпрометированные люди, лица с гипо- и ахлоргидрией. Перенесенная болезнь оставляет длительный иммунитет. Повторные заболевания редки. • Как и для всех кишечных инфекций, для холеры свойственна летне- осенняя сезонность.
Клиническая картина холеры • Инкубационный период равен 2— 3, реже 6 дням • Клиническая картина может быть атипичной формы ( «сухая» , молниеносная) и типичной. • Типичная форма - отмечает несколько этапов с переходом одного в последующий или же развитие заболевания может прекратиться на любом из них. Заболевание возникает остро. Начальным периодом холеры является понос — диарея, ему могут предшествовать легкие боли в животе. Затем появляется обильный жидкий стул калового характера. Испражнения учащаются и с каждым разом становятся все обильнее. Акт дефекации не сопровождается болезненностью, но после каждого испражнения больной чувствует нарастающую слабость. Температура тела нормальная или субфебрильная. Период диареи продолжается от нескольких часов до полутора суток.
холерный гастроэнтерит Рвота, как и понос, носит упорный характер, рвотные массы быстро теряют примесь пищи, характеризуются обилием жидкого содержимого. Испражнения в этот период теряют цвет, запах и характер кала, они напоминают рисовый отвар — беловатая жидкость с хлопьями— следствие слущенного эпителия кишечника. Иногда испражнения имеют розоватую окраску или вид мясных помоев. Больные холеой испытывают большую жажду, но выпитая жидкость не приносит облегчения, так как она тот час же выбрасывается при рвоте. Состояние больного резко ухудшается, он не может подняться с постели, нарушается деятельность сердечно- сосудистой системы. Пульс слабого наполнения, учащен, кровяное давление падает. Вследствие частого обильного стула и столь же обильной рвоты больной теряет огромное количество жидкости и солей, в результате чего наступает резкое обезвоживание организма и солевое голодание. Количество мочи прогрессивно уменьшается. Появляются мучительные судороги, особенно в области икроножных мышц. Период холерины продолжается не более 12 часов.
Нарастающая интоксикация, обезвоживание, потеря солей ведут к еще большим функциональным нарушениям, что приводит к следующему этапу болезни — холерному алгиду (algos — холод). В период алгида частота рвоты и поноса уменьшаются, моча почти перестает выделяться. Внешний вид больного холерой отражает холерную интоксикацию. Нарушается теплоотдача, температура падает до 35, 5—-35°. Кожа становится холодной, она покрыта липким потом, теряет свою эластичность, собранная в складки не расправляется. Больной адинамичен, но сознание сохраняет. Цианоз губ, носа, конечностей, голос становится беззвучным (афония), черты лица заостряются, глазные яблоки глубоко западают в орбитах. Судороги во всех группах мышц. Нарастает сердечно-сосудистая недостаточность, пульс частый, еле ощутим, кровяное давление падает — коллапс. С начала алгидного состояния до смертельного исхода или выздоровления проходят различные сроки; иногда смерть наступает через 3— 4 часа, в иных же случаях через 3— 4 дня. Летальность в алгидном периоде очень велика,
• Асфиктический этап (удушье вследствие недостатка кислорода), характеризующийся резким рецидивирующим удушьем; дыхание 40 — 45 в минуту, пульс нитевидный, нарастает резчайший цианоз. При этих явлениях быстро наступает смерть. В случаях выздоровления уменьшается интоксикация, реже становятся понос и рвота, следовательно, исчезает обезвоживание и солевое голодание, количество мочи увеличивается, сердечно-сосудистая деятельность восстанавливается и больной постепенно выздоравливает. В некоторых случаях период выздоровления может осложниться так называемым холерным тифоидом. При этом после 2— 3 дней благополучия наступает резкое ухудшение состояния больного, температура поднимается до 39— 40°, лицо становится красным, склеры инъецированы, появляется тифозное состояние, резко выражено возбуждение, бред. Больные погибают в коматозном (бессознательном) состоянии. Холерный тифоид связан с присоединением вторичной инфекции с развитием сепсиса.
Лабораторная диагностика • Материал для исследования – выделения от больных и носителей (испражнения, рвотные массы, желчь) объекты окружающей среды (вода, пищевые продукты, белье, смывы с объектов окружающей среды) • Экспресс диагностика - РИФ, реакция иммобилизации холерного вибриона, РПГА и ПЦР со специфическими праймерами • Посевы исследуемого материала на всех этапах выращивают в 1%-й пептонной воде 6 -8 ч, на щелочном агаре - не менее 14 -16 ч, а на плотных элективных средах TCBS и Мансура - 18 -24 ч.
Бактериологический метод (основной, 36 ч. ) • I Этап: посев исследуемого материала на 1%-ю пептонную воду, на щелочной агар и на плотные элективные среды TCBS и Мансура. • II Этап: Через 6 ч. : если есть рост – идентификация • Мазок с окраской по Граму • Определение подвижности в препарате «раздавленная капля» • РА на стекле с О 1 -агглютинирующей сывороткой и О 139 -сывороткой • Реакция иммобилизации холерных вибрионов • Нитрозо-индоловая реакция с пептонной водой Высев на 2 -ю пептонную воду, на щелочной агар и на плотные элективные среды TCBS и Мансура. • III Этап: через 12 ч. Изучают рост на щелочном агаре и 2 -й пептонной воде. Если есть рост – иденификация, если нет – через 12(24) ч. - изучаем рост на элективных средах и 2 м ЩА, и еще через 12 ч. – на 2 х элективных средах.
Идентификация чистой культуры

